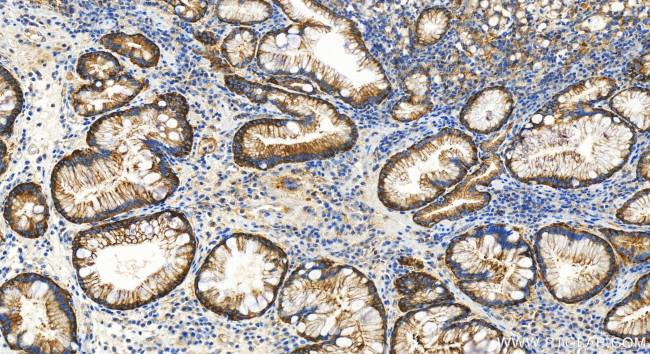
PARP4 Antibody in Immunohistochemistry (Paraffin) (IHC (P))

Search
Proteintech
PARP4 Recombinant Rabbit Monoclonal Antibody (240843C10)
{{$productOrderCtrl.translations['antibody.pdp.commerceCard.promotion.promotions']}}
{{$productOrderCtrl.translations['antibody.pdp.commerceCard.promotion.viewpromo']}}
{{$productOrderCtrl.translations['antibody.pdp.commerceCard.promotion.promocode']}}: {{promo.promoCode}} {{promo.promoTitle}} {{promo.promoDescription}}. {{$productOrderCtrl.translations['antibody.pdp.commerceCard.promotion.learnmore']}}
产品信息
84001-1-RR
种属反应
宿主/亚型
Expression System
分类
类型
克隆号
抗原
偶联物
形式
浓度
纯化类型
保存液
内含物
保存条件
运输条件
靶标信息
This gene encodes poly(ADP-ribosyl)transferase-like 1 protein, which is capable of catalyzing a poly(ADP-ribosyl)ation reaction. This protein has a catalytic domain which is homologous to that of poly (ADP-ribosyl) transferase, but lacks an N-terminal DNA binding domain which activates the C-terminal catalytic domain of poly (ADP-ribosyl) transferase. Since this protein is not capable of binding DNA directly, its transferase activity may be activated by other factors such as protein-protein interaction mediated by the extensive carboxyl terminus.
仅用于科研。不用于诊断过程。未经明确授权不得转售。
篇参考文献 (0)
生物信息学
蛋白别名: 193 kDa vault protein; ADP-ribosyltransferase (NAD+; poly (ADP-ribose) polymerase)-like 1; ADP-ribosyltransferase diphtheria toxin-like 4; ARTD4; H5 proline-rich; I-alpha-I-related; PARP-4; PARP-related; PARP-related/IalphaI-related H5/proline-rich; PH5P; poly (ADP-ribose) polymerase family, member 4; Poly [ADP-ribose] polymerase 4; poly(ADP-ribose) synthetase; poly(ADP-ribosyl)transferase-like 1; Protein mono-ADP-ribosyltransferase PARP4; Vault poly(ADP-ribose) polymerase; vault protein, 193-kDa; von Willebrand factor A domain containing 5C; VPARP
基因别名: ADPRTL1; ARTD4; KIAA0177; p193; PARP-4; PARP4; PARPL; PH5P; VAULT3; VPARP; VWA5C
UniProt ID: (Human) Q9UKK3
Entrez Gene ID: (Human) 143